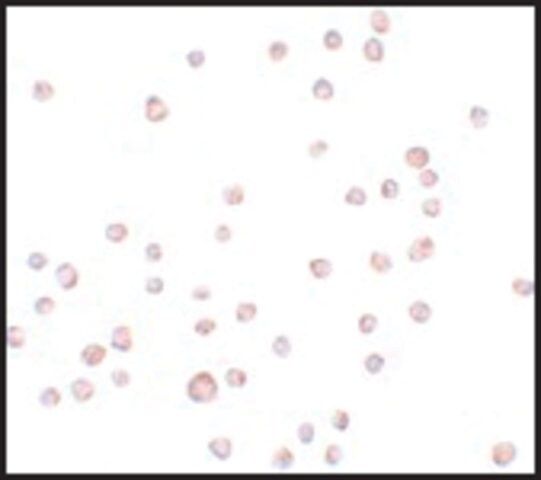

您的位置:首页 > 产品中心 > Anti-ENC-2 antibody produced in chicken
产品中心
Anti-ENC-2 antibody produced in chicken
| 产品编号: | 3359963 |
| 规格: | affinity isolated antibody, buffered aqueous solution |
| 包装规格: | 100 μG |
| 产品类别: | 进口试剂 |
| 品牌: | Sigma-Aldrich |
| 优惠价: | 立即咨询 |
产品别名
Anti-ENC-2 antibody produced in chicken
Anti-KLHL25
Anti-Kelch-like protein 25
Anti-Ectoderm-neural cortex-2
基本信息
| NACRES | NA.41 |
| Immunogen【免疫原】 | ENC-2 antibody was raised against a 14 amino acid peptide near the center of human ENC-2. |
| Features and Benefits【特点和优势】 | Evaluate our antibodies with complete peace of mind. If the antibody does not perform in your application, we will issue a full credit or replacement antibody. Learn more. |
| Linkage【联系】 | The action of this antibody can be blocked using blocking peptide SBP3500164. |
| Physical form【外形】 | Supplied in PBS with 0.02% sodium azide. |
产品性质
| biological source【生物来源】 | chicken |
| Quality Level【质量水平】 | 100 |
| conjugate【偶联物】 | unconjugated |
| antibody form【抗体形式】 | affinity isolated antibody |
| antibody product type | primary antibodies |
| clone【克隆】 | polyclonal |
| form【形式】 | buffered aqueous solution |
| species reactivity | human |
| technique(s) | indirect ELISA: suitable western blot: suitable |
| NCBI accession no.【NCBI登记号】 | AAV51405 |
| UniProt accession no.【UniProt登记号】 | Q9H0H3 |
| shipped in【运输】 | dry ice |
| storage temp.【储存温度】 | −20℃ |
| Gene Information | human ... KLHL25(64410) |
安全信息
| Storage Class Code【储存分类代码】 | 12 - Non Combustible Liquids |
| WGK | WGK 2 |






